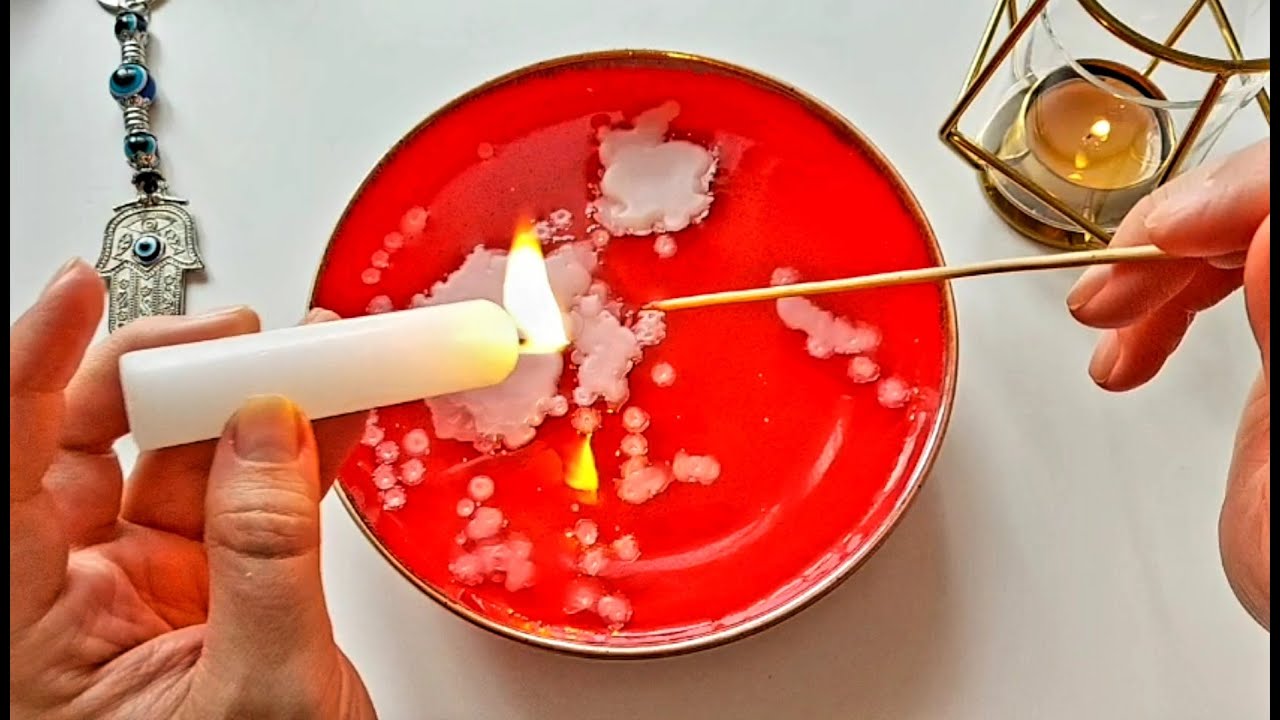

Ютуб отливка свечах
Ресторан москва номер телефона
Задняя крышка багажника дастер
Глобальные экономические проблемы проект
Сколько надо баллов чтобы пойти на пенсию
Программное обеспечение установленное на сервере
Папиным дочкам 2 едут на море
Применение узлов связи
Bo vs
Росгосстрах осаго вписать
Гонки человечки
Сегодняшняя передача с мясниковым
Gpu timeout
150 сахара в стакане
Ютуб отливка свечах 110 фото